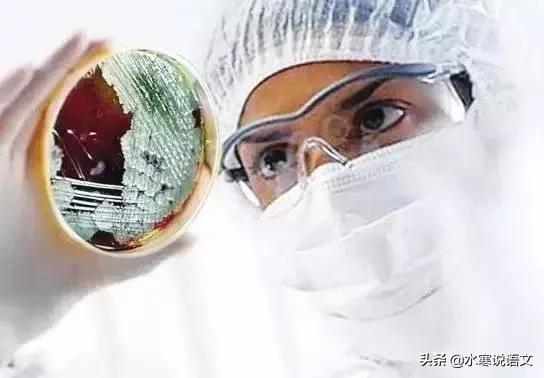
说疫字的故事,关于疫病说说

今天说说“疫”以及与之相关的汉字。
我不是医学专家,只是一线语文老师,所以,只是从语文的角度给大家说说这些字。
要说“疫”,得先从“疒”说起,这个字就是我们熟悉的所谓病字头,但是不读bìng,而读nè。
《说文解字·疒部》:“疒,倚也。人有疾痛也,象倚箸之形。”也就是说,这个字意思是“人有病痛而倚靠休养的样子”。人生病了大多愿意找个地方靠一下。

看了上面关于“疒”这个字的字源字形的演变,就可以更清楚更形象地解这个字了。《说文》中的“象倚箸之形”中的“箸”也不是我们现在说的“筷子”,毕竟,人那么大的块头,一根小小的筷子是无法倚靠的。这个“箸”是竹子,更具体来说,可以理解为很可能是竹制的床,人倚靠(躺)在上面,甲骨文中的字形的方向是有所调整的。你看,在甲骨文中甚至描述了人在生病时常有的出汗(人身下的两点正是汗滴之形)的状况。
说完了“疒”,再说说“病”。
病,形声。疒形丙声。本义:上古时指重病。《说文》中关于“病”的解释就是“疾加也。”
所谓“疾加也”,用现在的话来说就是“病得严重了”。这又牵出了另外一个带有病字头的字——“疾”,“疾病”现在连用,不太有人刻意区别它们的意思,但是,在古代两个字意思却是有区别的。
“疾”,会意。甲骨文字形,从大(人),从矢,字形象人腋下中箭。《说文》中关于疾的解释是“病也”。段玉裁注说:“析言之则病为疾加,浑言之则疾亦病也。”

所谓“析言”就是拆开来说,拆开来说“病为疾加”,那当然反之“疾”就不是重病,而是小病,是轻微的病。所谓“浑言”就是合在一起说,不加区分,那“疾”就是“病”,“病”也是“疾”。我猜测,古人觉得腋下中箭,不是头部中箭,也不是心脏中箭,并非致命之伤,因此,将“疾”认为是小病。
关于“疾”与“病”的细微区别,在初中所学的《扁鹊见蔡桓公》一文中表现得特别清楚。
最初,扁鹊见蔡桓公时说:“君有疾在腠理,不治将恐深。”那只是在皮肤纹理上的小病。过了一段时间,扁鹊再次见到蔡桓公时说,“君之病在肌肤,不治将益深。”这时候病严重了,已经到肌肉了。再后来,扁鹊说:“君之病在肠胃,不治将益深。”病已经进入肠胃了。最后一次见面,扁鹊见到蔡桓公转身就跑。蔡桓公派人追问为什么,扁鹊说:“疾在腠理,汤熨之所及也;在肌肤,针石之所及也;在肠胃,火齐之所及也;在骨髓,司命之所属,无奈何也。今在骨髓,臣是以无请也。”
当病侵入到骨髓的时候,扁鹊这样的神医也没办法了,而这一切,都是蔡桓公讳疾忌医的结果。
两千多年前,《黄帝内经》中提出“上医治未病,中医治欲病,下医治已病”,说的是医术最高明的医生并不是擅长治病的人,而是能够预防疾病的人。《扁鹊见蔡桓公》这个故事很生动地说明了这个道理。因此,后世也有故事附会说“上医治未病……”这段话是扁鹊所说的,但不管是谁说的,都值得信服,毕竟是极有道理的话。
其实不仅仅是一般的疾病,“瘟疫”也是如此,如果提前采取一些预防的措施,或者在刚刚发生苗头时就及时扑灭,就不至于发展到四处蔓延,人人自危的程度,这在人类历史上有各种教训与经验可循。可惜,不管是个体也好,还是群体也要,有很多时候人也和猪一样,也是“记吃不记打”的。所以,我们会经常看到教训的不断重演,而不是经验积累之后避免无端的损失。
回过头来追溯一下“瘟疫”这两个字的字源问题。
瘟:形声。从疒,昷声。本义:瘟疫。
疫:形声。从疒,役省声。本义:瘟役。《说文》的解释是:“疫,民皆疾也。”所谓“民皆疾”就是老百姓都病了。
《周礼正义》中有这样的文字:“谚日:鬻棺者欲岁之疫。非憎*欲人**杀之,利在于人死也。”卖棺材的人希望每年都发生瘟疫。比喻损人利己。今天的囤积口罩,高价售出,抢*论发**文,争名夺利者,也正是这样的“鬻棺者欲岁之疫”的心理吧。
“瘟”与“疫”两个意思相近的单音节词语,慢慢组合在一起,成为一个双音节词语,这是现在古汉语中的单音节词到现代汉语中的双音节词中最常见的转化方式。两者合在一起,表示“急性传染病”。
绝大多数和“病”有关的字,都从“病字头”,不一一举例,只是列举一些常见的。
比如,“疮”形声。从疒,仓声。本义:皮肤上肿烂溃疡的病。老百姓常说某人很坏,就说这个人“头顶上生疮,脚底下冒脓。”今日,非常时刻非常人,看看某些人的表现,比如,在电梯里往按钮上吐口水的;明知染疾,还四处乱串的;还有那些尸位素餐,寡廉鲜耻的,都可以配得上这句“头顶上生疮,脚底下冒脓”吧。
三国时期的才子曹植在《说疫气》一文中记载,“建安二十二年(公元217年)疠气流行。家家有僵尸之痛,室室有号泣之哀。”然后他认为造成瘟疫流行的原因是“此乃阴阳失位,寒暑错时,是故生疫。”
最有意思的是最末一句“而愚民悬符厌之,亦可笑也。”近两千年前,能有这种认识,殊为难得。看看今天,抢双黄连,各种歪门左道,各种阴阳符咒,也属于“愚民悬符厌之,亦可笑也。”
说到“疮”,就想到“瘢”。“瘢”是创伤或疮疖等愈后的疤痕。“疮瘢”连用,表示疮伤愈合后留下的痕迹。又由“疮瘢”想到另外一个同音词“创瘢”,其实两者的意思差不多,都是疤痕之意,只不过可能成因稍有不同。
有一句谚语是这么说的:
“吴王好剑客,百姓多创瘢;楚王好细腰,宫中多饿死。”
自古以来,“上有所好,下有所效”者多矣。给老百姓带来的危害也多矣。当上有所好,下有所效成为一种流行性的社会疾病时,“瞒”和“骗”就不可避免地发生了。
最后说一个常见的带病字头的字吧。那就是“瘦”。
瘦:形声。从疒,叟声。从疒,表明与疾病有关。本义:肌肉不丰满。
人类几千年的历史,大多是饥饿的历史,大多数人都吃饱了饭,实际上并没有多少年的时间。所以,古人大多以胖为美,以瘦为病。今人则正相反。
在这个憋在家里出不去的时候,很容易长胖的,但也别着急减肥。毕竟,关键时刻,胖子还有自身的脂肪可供消耗一阵子的。